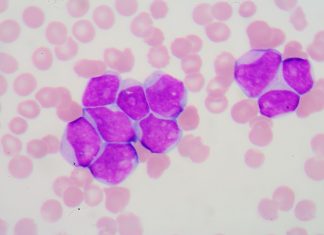
Leucemie limfatica cronica, tratamente noi

Cataplexia: ce este si cum se gestioneaza
Cataplexia este o afectiune care genereaza paralizia musculara temporara, reducand calitatea vietii celor care sufera de ea. Din fericire, identificarea precoce imbunatateste prognosticul. Pierderea tonusului muscular si slabiciunea sunt afectiuni legate de...
6 tipuri de flegmon si ce trebuie sa stii despre ele
Sursa foto: Shutterstock Nu intotdeauna este usor de facut diferenta dintre un abces si un flegmon: abcesul: este limitat doar la zona infectata;flegmonul: se extinde de-a lungul tesutului conjunctiv. In acest...
Viata unui pacient diabetic – 7 aspecte mai putin stiute
Sursa foto: shutterstock.com Diabetul zaharat este o afectiune ce creeaza disconfort multor persoane. Cu toate ca nu exista vindecare pentru aceasta, se poate gestiona. Sunt insa diverse lucruri pe care este indicat sa...
Go Vita – aliatul sanatatii tale cu cele mai bune suplimente
Nu exista viata fara zinc. Mineral esential, care desi este prezent in organism intr-o concentratie relativ redusa, are roluri foarte bine determinate, fiind un element de care depinde in mod direct functionarea corecta a...
Tratament psihologic pentru autism
Exista multe tratamente pentru autism care nu sunt sustinute de stiinta. In acest articol va explicam care sunt cele mai studiate tratamente psihologice. Exista mai multe tratamente care, astazi, sunt folosite pentru...
Cele mai frecvente boli de inima si metodele prin care pot fi descoperite
Buna functionare a organismului este dependenta de activitatea inimii. Exista numeroase afectiuni care pot avea un impact negativ asupra functionarii inimii. Unele dintre acestea pot fi mai putin grave, in timp ce altele pot...
Alimente si corpi straini in plamani: cauze pentru care se poate intampla acest lucru
In general, stim ca alimentele trec din gura in gat si acolo continua pana ajung in stomac si completeaza procesul de digestie. Cu toate acestea, uneori, acest lucru nu se intampla. De ce alimentele...
Leucemie limfatica cronica, tratamente noi
Un studiu a descifrat genomul complet al leucemiei limfocitare cronice si o harta de inalta rezolutie a functiilor acesteia. Prestigioasa revista stiintifica Nature Medicine a publicat foarte recent un studiu stiintific realizat...
5 diete pentru a slabi rapid
Ai nevoie sa slabesti rapid? Daca ceea ce iti doresti este sa urmezi o dieta pentru slabit in cateva zile, pe parcursul acestui articol vei descoperi 5 diete pentru a slabi rapid. Acestea dureaza...